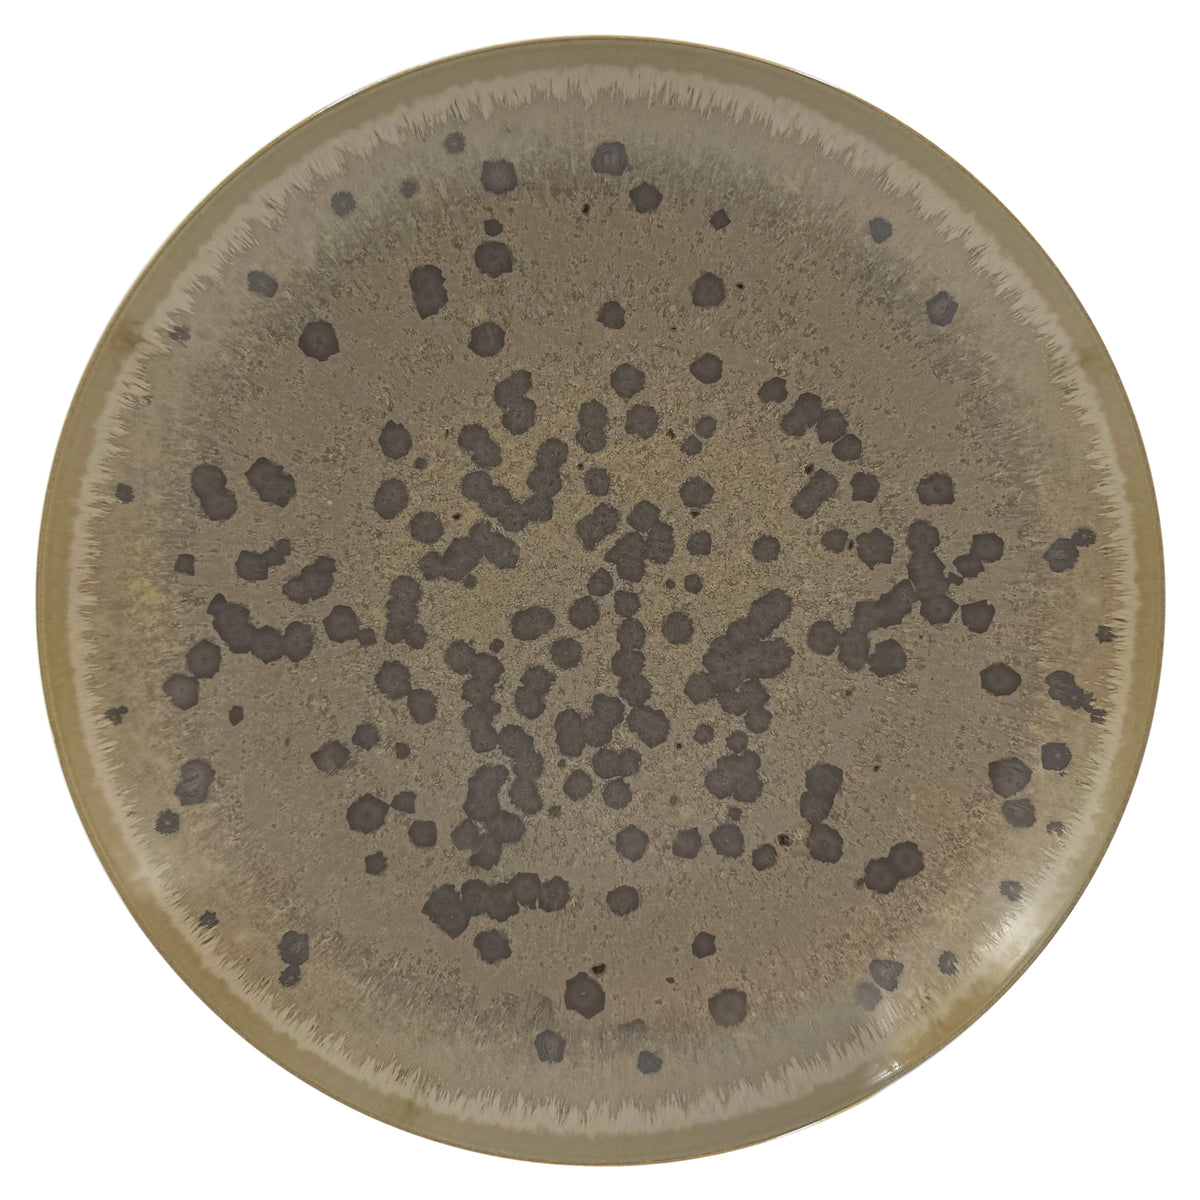
ZOULOU - Plat plat Maxi

Promotion
ZOULOU - Plat plat Maxi
Ref : HOR5043ZOULZOUL000
HOR5043ZOULZOUL000
ø 35 cm
$510.00 USD
Plus d’informations

Plat finement décoré, qui pourra vous servir quotidiennement, pour la présentation de tout type de plats. Un produit pour agrémenter votre service de table ou à offrir. Existe en trois formats (maxi, plat médium et creux).
Entretien
MICRO-ONDES
Nos pièces en porcelaine ont été cuites à 1400°C et peuvent donc parfaitement résister à une température élevée.
Tous nos modèles peuvent aller au micro-ondes sans dommage à l’exception de ceux qui sont décorés avec des métaux précieux (or, argent ou platine).
Attention toutefois aux écarts de température entre le chaud et le froid (par exemple de passer du réfrigérateur au four), la pièce risquerait de se fendre.
LAVE-VAISSELLE
Tous nos modèles peuvent aller au lave-vaisselle sans dommage à l’exception de ceux qui sont décorés avec des métaux précieux (or, argent ou platine). Veillez à choisir un programme à basse température et respecter la dose de produit recommandée. Veillez à ce que les pièces ne s’entrechoquent pas.
Pour un nettoyage à la main, nous recommandons l’usage d’une éponge douce et d’un liquide vaisselle classique.
Livraison & retours
Livraison en France métropolitaine
Livraison effectuée au plus tard dans les cinq jours ouvrés à compter de la réception du mail d’envoi de votre commande.
Livraison offerte à partir de 100 euros d’achat pour la France métropolitaine (y compris Corse et Monaco).
Livraison en Europe
La vente sur notre e-shop est possible depuis les pays suivants :
Allemagne, Belgique, Danemark, Espagne, Finlande, Grande Bretagne,
Grèce, Irlande, Italie, Luxembourg, Pays Bas, Portugal, Suède et Suisse.
Livraison effectuée dans les sept jours ouvrés à compter de la réception du mail d’envoi de votre commande.
Vérifications à effectuer à la livraison
Le Client doit contrôler, avant de procéder à la signature du bon de livraison :
- L’état apparent du ou des colis.
- L'état des produits à l'intérieur du ou des colis.
- La bonne conformité des produits par rapport au bon de livraison d'une part et à la marchandise commandée d'autre part.
Faute de réserves précises formulées par le Client, la livraison sera présumée conforme.
Pour en savoir plus, lire l’article 8 de nos conditions générales de vente.
Retours
Dans le cas où le produit acheté en ligne ne vous conviendrait pas, vous pouvez exercer votre droit de rétractation, sans avoir à motiver votre décision, jusqu'à quatorze jours après la réception de l’article concerné.
Les frais de renvoi de l’article seront alors à votre charge. Le remboursement interviendra dans les quatorze jours suivant la réception des articles retournés. Il est précisé qu'aucun remboursement n'est effectué en magasin.
Pour en savoir plus, lire l’article 9 de nos conditions générales de vente.























